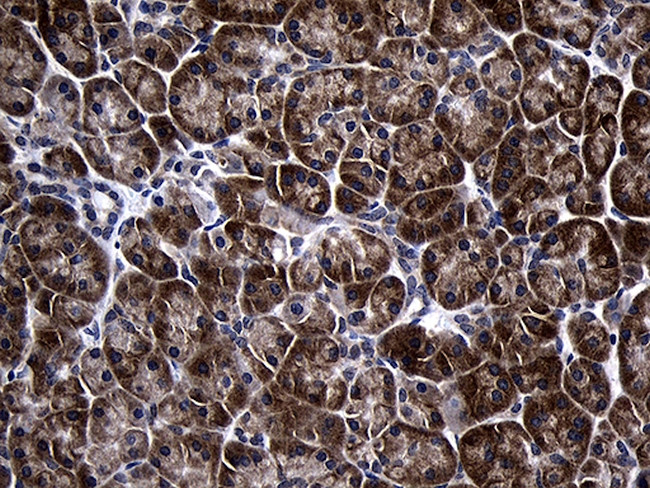
TINF2 Antibody in Immunohistochemistry (Paraffin) (IHC (P))

Search
OriGene
TINF2 Monoclonal Antibody (OTI2C12), TrueMAB™
{{$productOrderCtrl.translations['antibody.pdp.commerceCard.promotion.promotions']}}
{{$productOrderCtrl.translations['antibody.pdp.commerceCard.promotion.viewpromo']}}
{{$productOrderCtrl.translations['antibody.pdp.commerceCard.promotion.promocode']}}: {{promo.promoCode}} {{promo.promoTitle}} {{promo.promoDescription}}. {{$productOrderCtrl.translations['antibody.pdp.commerceCard.promotion.learnmore']}}
图: 1 / 3
TINF2 Antibody (CF809776) in IHC (P)



产品信息
CF809776
种属反应
宿主/亚型
分类
类型
克隆号
抗原
偶联物
形式
浓度
规格
纯化类型
保存液
内含物
保存条件
运输条件
产品详细信息
For reconstitution, we recommend adding 100 µL distilled water to a final antibody concentration of about 1 mg/mL. To use this carrier-free antibody for conjugation experiments, we strongly recommend performing another round of desalting. (Zeba Spin Desalting Columns, 7KMWCO, 0.5 mL, Product # 89882)
靶标信息
TRF1 is a negative regulator of telomere length maintenance. Recently two proteins, tankyrase and Tin2, which bind to mammalian TRF1, have been identified. Tankyrase is a protein with homology to ankyrins as well as to the catalytic domain of poly (adenosine diphosphate-ribose) polymerase (PARP). Tankyrase localizes to telomeres by binding to the telomeric repeat binding factor 1 (TRF1) through its ankyrin repeats. Tankyrase exhibits PARP activity functioning as acceptors for adenosine diphosphate (ADP)-ribosylation. Since ADP-ribosylation of TRF1 diminishes its ability to bind to telomeric DNA, this suggests that telomere function in human cells is regulated by poly (ADP)-ribosylation. Both the cell cycle and TRF1 may regulate the subcellular localization of tankyrase. The cDNA coding for TIN2 protein was isolated as interacting partner of TRF1 from a yeast two-hybrid cDNA library screening. Tin2 localizes to telomeres and is essential for proper regulation of telomere length. TIN2, like TRF1, is widely and constitutively expressed, suggesting that these proteins act together to counterbalance telomere elongation by telomerase. However, endogenous TIN2, like endogenousTRF1, is not highly expressed, and therefore may be difficult to visualize by immunostaining in certain cell systems.
仅用于科研。不用于诊断过程。未经明确授权不得转售。
篇参考文献 (0)
生物信息学
蛋白别名: TERF1 (TRF1)-interacting nuclear factor 2; TERF1-interacting nuclear factor 2; tin; Tin-2; TRF1-interacting nuclear factor 2; TRF1-interacting nuclear factor 2; telomere-associated protein; TRF1-interacting nuclear protein 2; unnamed protein product
基因别名: AW552114; D14Wsu146e; DKCA3; DKCA5; TIN2; TINF2
UniProt ID: (Human) Q9BSI4
Entrez Gene ID: (Human) 26277, (Mouse) 28113, (Rat) 290232